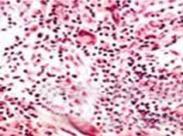
迪格奧爾格綜合征

原發性T細胞免疫缺陷所致的免疫缺陷綜合征的患兒所表現的主要是細胞介導的免疫阻抑,占原發性免疫缺陷病的5%~20%。T細胞缺陷也會間接地影響被抗原啟動的T細胞激活的效應細胞,如單核巨噬細胞和B細胞。嚴重的T細胞缺陷多于出生1年內就產生臨床征象,可表現為不同免疫反應系統的聯合免疫缺陷,輕度T細胞缺陷可遲至成年才出現癥狀。包括胸腺發育不全,低鈣血癥,先天性心臟疾病和面部畸形。
大部分病例為部分迪格奧爾格綜合征,即指胸腺未受損害,其T細胞數量及功能正常,很少并發感染。少數病例為完全迪格奧爾格綜合征,即指胸腺缺陷者,其中部分病兒胸腺缺陷也為部分性,其免疫功能缺陷隨時間推移而逐漸好轉。完全性迪格奧爾格綜合征患者的T細胞數量和功能顯著下降,具有明顯的感染傾向。